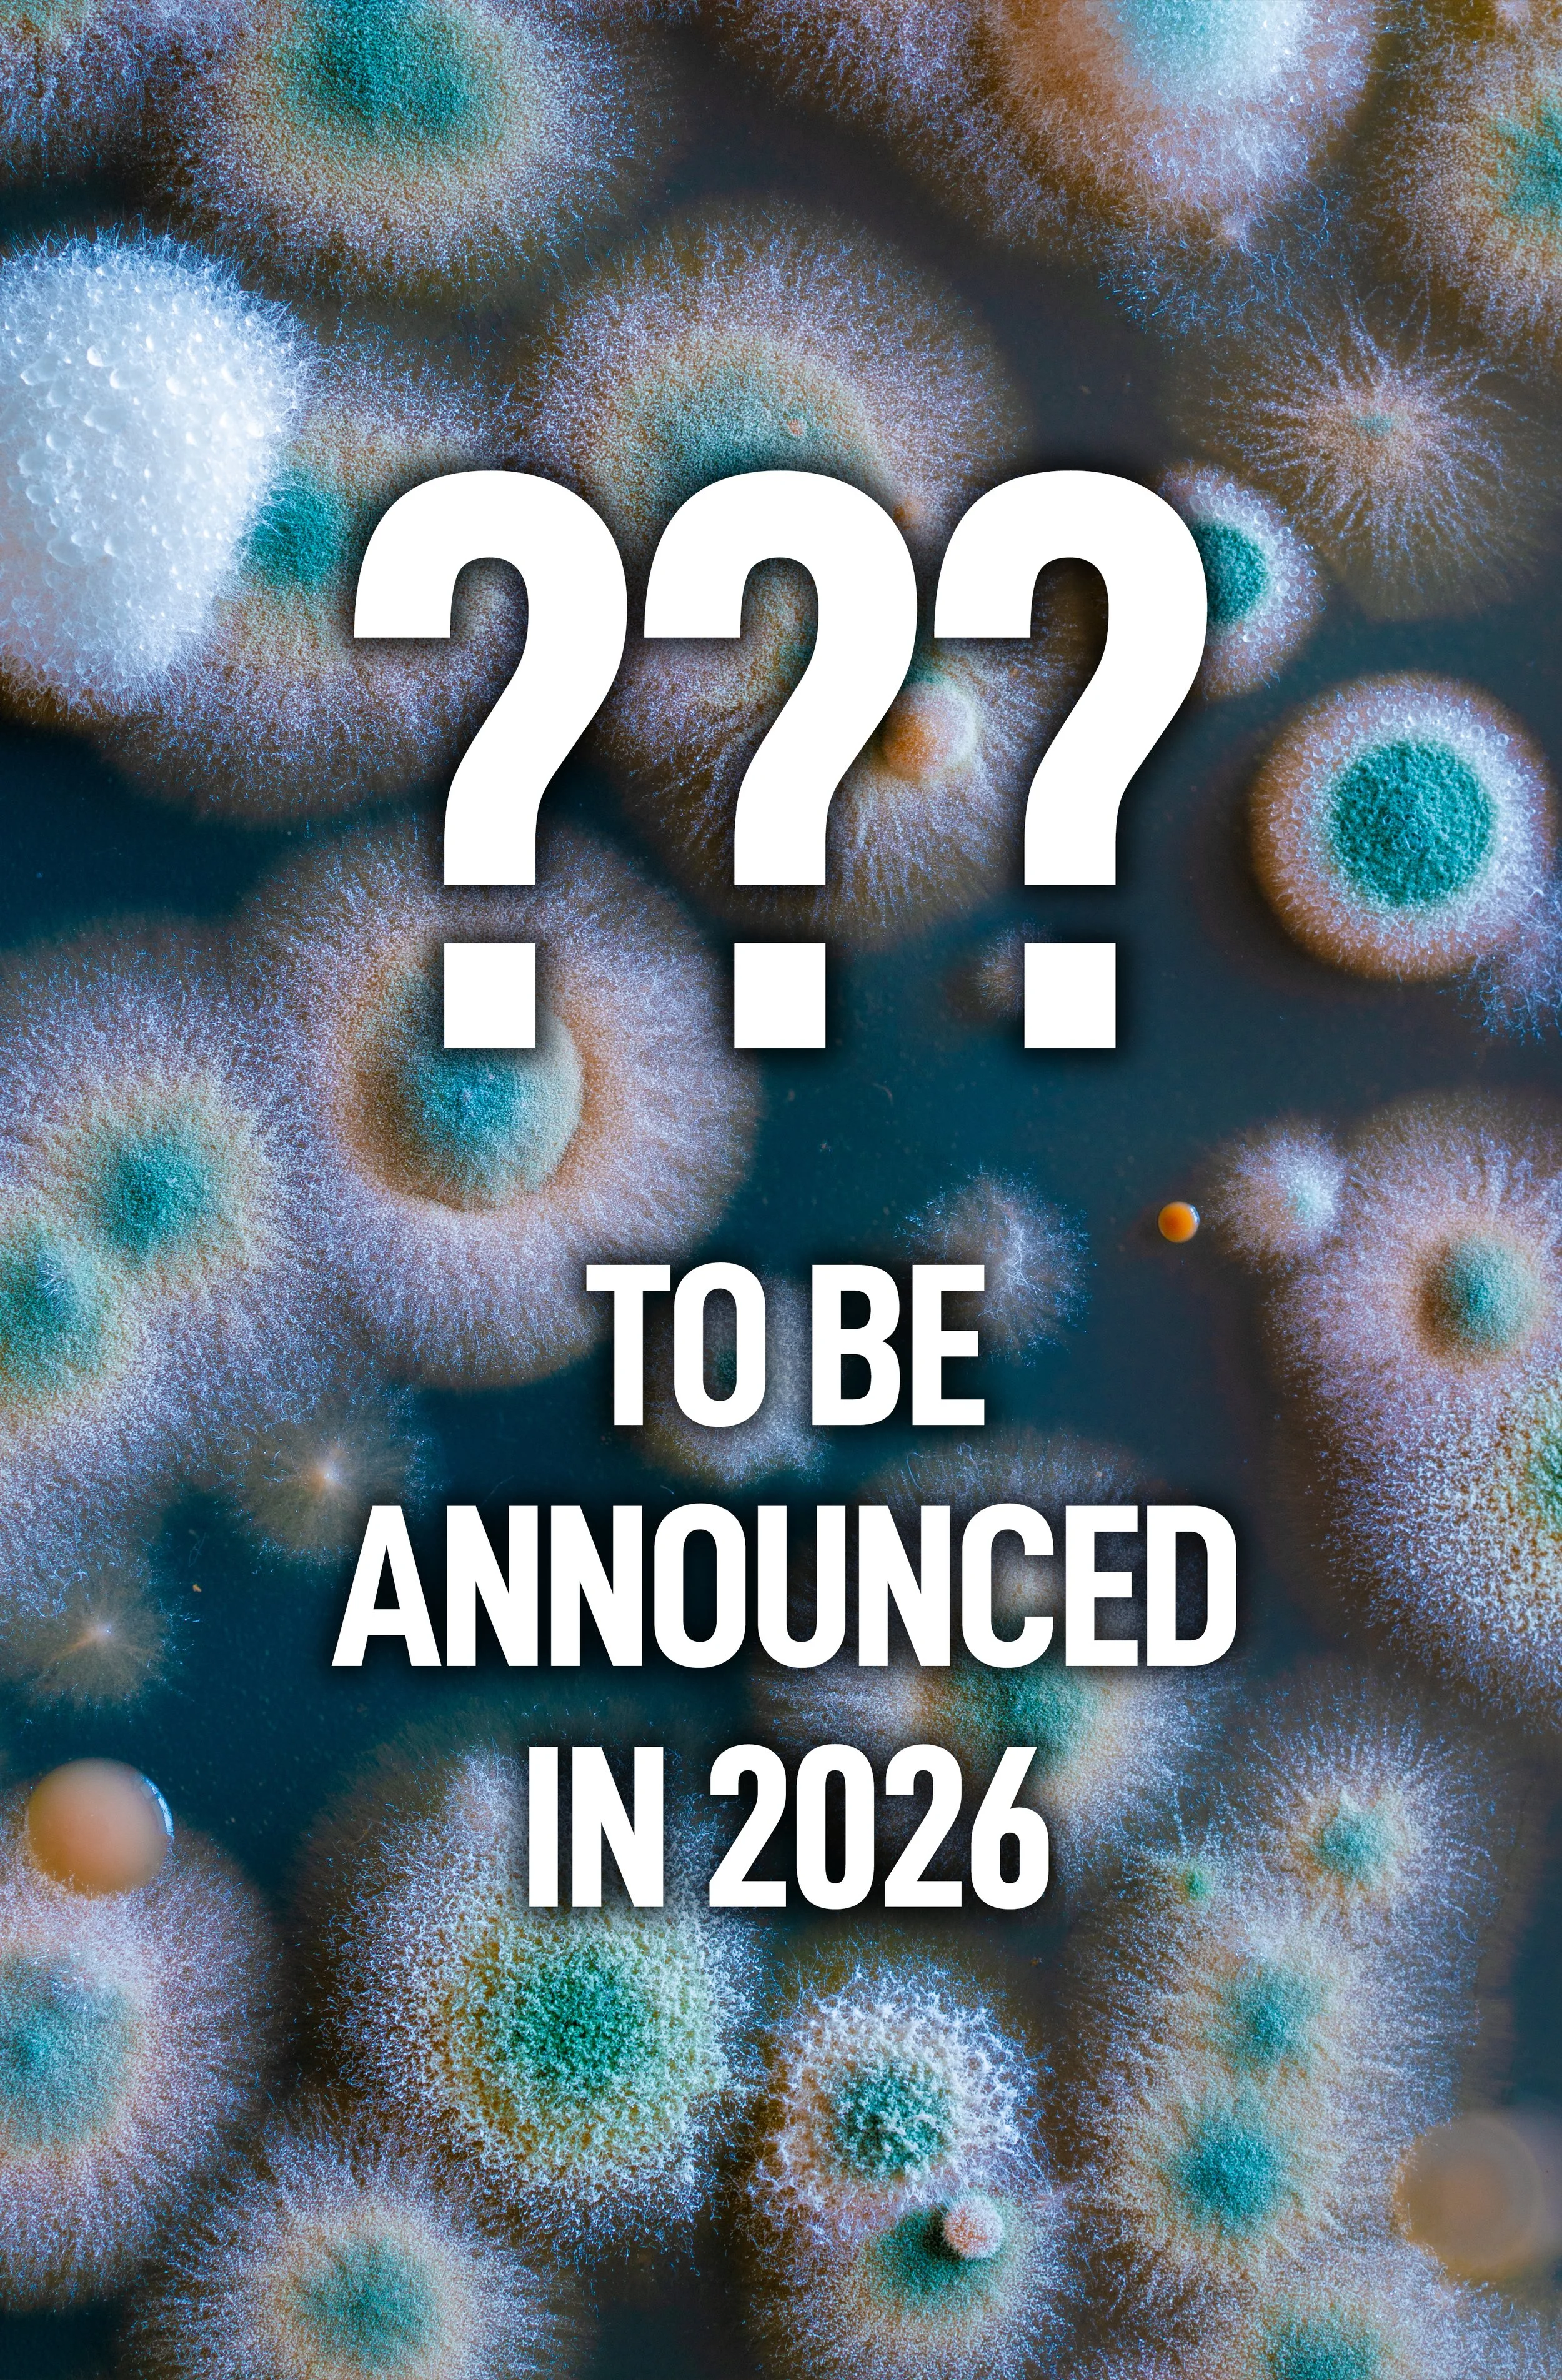

MY BOOKS
THE FUNGALVERSE (SHARED UNIVERSE):
MUSHROOM BLUES (The Hofmann Report #1)
BLADE RUNNER, TRUE DETECTIVE, and DISTRICT 9 meld with the weird worlds of JEFF VANDERMEER, PHILIP K. DICK, and CHINA MIÉVILLE in Adrian M. Gibson’s award-winning fungalpunk noir debut.
Now with a foreword by Nicholas Eames and original interior artwork. Available in paperback, hardcover, eBook and audiobook.
A MURDER MOST FUNGAL (The Hofmann Report #1.5)
NEW FUNGALVERSE SIDE STORY NOVEL RELEASING IN SPRING 2026
THE HOFMANN REPORT #2
TBA 2026
SECRET GRAPHIC NOVEL PROJECT
TBA 2026
ANTHOLOGIES
THE BOOK OF SPORES: A Fungal SFF Anthology
Hidden in the vaults of a world-spanning library lie the records of a mysterious book, one made of mold and magic. Varied accounts of its existence remain scattered throughout the multiverse, but when an archivist attempts to bring its pages together, she will learn how dangerous a book—and her own ambitions—can be . . .
Collecting fungal tales from across countless universes, this FanFiAddict anthology spotlights the best of fantasy, science fiction, and horror. Prepare for your imagination to be colonized by THE BOOK OF SPORES.
The Book of Spores is a mind-altering, multi-genre anthology, featuring 17 strange stories by authors from the FanFiAddict book blog and SFF Addicts Podcast. This anthology brings together an incredible array of writers whose stories will spread across the multiverse like spores.
SECRET ANTHOLOGY PROJECT
TBA 2026